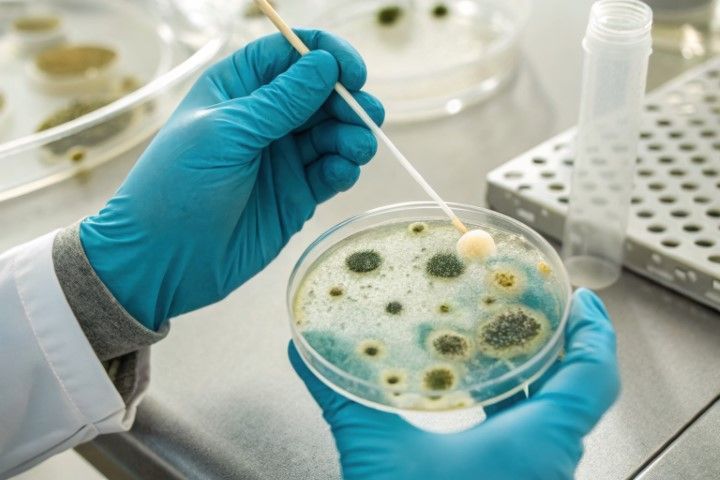
Hands in blue gloves, holding a Petri dish with mold cultures and a cotton swab. Laboratory setting.

Mold Inspection Company in West Hollywood CA
West Hollywood Mold Inspection Pros provides thorough mold inspection services for homeowners and property managers in West Hollywood. Our certified inspectors combine visual assessments, infrared scanning, moisture mapping, and air testing to identify hidden growth, moisture intrusion, and contamination sources. We use calibrated instruments and partner with accredited laboratories for precise analysis, then deliver clear, prioritized reports that explain findings, health considerations, and recommended next steps. Whether you're buying a property, suspect water damage, or need routine building safety checks, we focus on accurate diagnostics and practical remediation planning. Contact us for same-week appointments and comprehensive documentation suitable for insurance or real estate needs.
What We Offer
We provide a full range of services tailored to residential and commercial properties, including air testing, moisture mapping, infrared scanning, and laboratory analysis. Our approach combines on-site testing with detailed measurements to locate active mold growth, identify moisture sources, and assess airborne spore levels so you can make informed decisions. Our team follows industry best practices to produce clear, actionable reports and remediation plans. Clients receive prioritized recommendations, documented findings, and guidance for next steps that protect occupants and preserve property value. Fast scheduling, certified technicians, and transparent communication are central to our service.
- Surface Sampling
- Air Testing
- Moisture Mapping
- Mold Assessment
- Infrared Scanning
- Visual Inspection
- Laboratory Analysis
- Remediation Planning
- Detailed Reporting
- Water Damage Inspection
Book a Consultation Today
Have a question? We’re here to help. Send us a message and we’ll get in touch as fast as we can.
Mold Removal Company Near Me
Ready to take the next step? We provide thorough, science-driven evaluations to identify hidden mold, measure airborne spores, map moisture pathways, and produce clear laboratory-backed results. We offer air testing, moisture mapping, infrared scanning, visual inspection, laboratory analysis, remediation planning, and water damage inspection — all delivered with transparent reporting so you know exactly what’s happening in your home. Whether you need a one-time assessment or a plan to guide remediation, our team combines fast scheduling, professional communication, and practical recommendations to protect your indoor air quality and property value. Request a quote today and let our experienced inspectors evaluate your space, interpret data, and give you the informed next steps you can trust.

Why Choose Our Business
When it comes to mold inspection, homeowners want accurate information, clear guidance, and a team that responds quickly and professionally. We combine technical expertise with straightforward communication so you understand both the problem and the solution. Our approach starts with a comprehensive visual inspection and expands to include targeted air testing, moisture mapping, and infrared scanning where needed. We partner with accredited laboratories to confirm findings and then translate results into an actionable remediation plan. From emergency water damage checks to preventive assessments, our goal is to protect your health and your home by delivering reliable data and honest recommendations, backed by experience and a commitment to customer care.
Certified Inspectors
Our inspectors are trained, certified, and experienced in recognizing the subtle signs of mold and moisture intrusion. We follow industry best practices for sampling, documentation, and safety, so you can trust that inspections are thorough and reliable. Certification means our team understands mold behavior, building science, and diagnostic techniques, reducing guesswork and avoiding unnecessary work. When we inspect your home, we provide a professional assessment that stands up to scrutiny, whether for personal peace of mind, real estate transactions or insurance needs. Our certifications also reflect continuing education, so we stay current with evolving standards and technologies to deliver accurate results.
Advanced Testing
We use an array of diagnostic tools to pinpoint problems that are invisible to the naked eye. Air testing helps quantify airborne spore levels, while moisture mapping and infrared scanning reveal hidden damp areas behind walls and ceilings. When samples are collected they are processed by accredited laboratories to provide objective, scientific data that supports accurate conclusions. This layered testing strategy minimizes uncertainty and helps prioritize remediation work based on actual conditions, not assumptions. By combining field instruments with lab analysis, we deliver a clearer picture of your indoor environment so remediation can be targeted, efficient and cost-effective.
Clear Reporting
We translate technical findings into easy-to-understand reports that include photos, measurement data, laboratory results, and practical recommendations. Our reports clearly identify affected areas, likely sources of moisture, and the level of concern, then outline step-by-step remediation options and monitoring suggestions. Clear reporting helps homeowners, contractors, and insurance adjusters move forward with confidence and reduces delays caused by miscommunication. We prioritize transparency. Meaning, you receive complete documentation that supports repairs or insurance claims, and we remain available to explain results and assist with follow-up testing once remediation is complete.
Fast Response
Timely action is critical when mold or water damage is suspected, and we prioritize prompt scheduling and rapid onsite evaluations. Our team is prepared to perform emergency water damage inspections, identify active moisture issues, and recommend immediate containment steps to prevent further spread. Fast response reduces the extent of remediation required and helps protect indoor air quality and structural components. We also provide clear timelines for sampling, lab turnarounds and report delivery so you know what to expect. When you contact us, our process is efficient, organized and focused on resolving the situation with minimal disruption to your household.
Choosing a mold inspection partner means choosing accuracy, clarity, and practical guidance. Our services are built around comprehensive assessments from visual inspection and infrared scanning to air testing, moisture mapping, and laboratory analysis, followed by remediation planning and detailed reporting. We emphasize fast, professional service, clear communication, and science-backed results so you can make informed decisions about repairs and ongoing prevention. Whether addressing a suspected problem or conducting a routine check, our approach protects your indoor air quality and helps preserve your home. Contact us for a precise evaluation and an actionable plan tailored to your property and concerns.
Discover Who We Are
Finding mold in your home or business can be stressful and confusing. You may notice a musty smell, dark spots on walls, or experience allergy symptoms that seem to get worse indoors. When these signs appear, it is important to act quickly and speak with professionals who understand how mold grows, spreads, and affects indoor spaces. We provide professional services tailored for homeowners, renters, real estate professionals, and property managers who need clear, reliable answers about indoor mold concerns. Our team focuses on fast, noninvasive evaluations that prioritize occupant health and the longevity of the building. We combine thorough visual inspections with targeted air testing, moisture mapping, infrared scanning, and laboratory analysis so you get an accurate picture of contamination and moisture sources. Whether you suspect visible mold, have unexplained odors, experienced recent water intrusion, or need documentation for a sale or insurance claim, our approach is designed to be transparent and easy to understand. We explain findings in plain language, outline practical remediation planning, and deliver detailed reporting so you can make informed decisions about repairs, safety, and prevention. We aim to remove uncertainty and help you restore a healthy indoor environment quickly and confidently.

Perks of Hiring Mold Inspection Services
Hiring a professional Mold Inspection service brings clarity, safety, and long-term savings when dealing with suspected mold or moisture problems. Our inspections identify hidden moisture pathways, distinguish active growth from historical staining, and use objective testing methods to quantify airborne spores and surface contamination. This reduces guesswork and prevents unnecessary removals or missed hotspots that could lead to recurring issues. Timely, accurate inspections also help protect household health, support insurance claims, and preserve property value by documenting conditions and recommended actions. For residents and property owners, working with a trained inspection team means faster diagnoses, evidence-based remediation plans, and comprehensive reporting that contractors and insurers can rely on. We focus on practical solutions that address root causes, not just visible symptoms, so the investment in inspection helps avoid larger, costlier problems down the line.
Rapid, Reliable Response
Fast response matters when mold or water issues threaten a home. We prioritize timely scheduling and on-site evaluations so problems are assessed before they escalate. Early detection allows us to pinpoint moisture sources, evaluate the extent of contamination, and recommend containment and remediation steps that limit damage and health risks. A rapid inspection also preserves evidence for insurance or real estate transactions and shortens the time between discovery and corrective action. By arriving prepared with specialized tools, we complete thorough assessments efficiently and provide clear next steps immediately. Choosing a service that responds quickly reduces disruption to daily life and helps prevent small issues from becoming expensive repairs.
Accurate, Objective Testing
Objective testing is essential to separate perception from reality when mold is suspected. We use calibrated instruments and validated sampling protocols for air testing, surface swabs, and bulk samples to determine species, concentration, and distribution. Laboratory analysis translates samples into actionable data, helping us differentiate active growth from dormant spores or historical residues. This accuracy prevents unnecessary remediation and ensures contractors address the correct areas with appropriate methods. Our reports interpret lab results in plain language and link findings to recommended steps, making it easier for homeowners, landlords, or agents to make informed decisions. Relying on objective testing safeguards health and finances by targeting remediation where it’s truly needed.
Comprehensive Documentation
Thorough documentation supports effective remediation and protects your interests. We produce detailed reports that include inspection findings, moisture maps, infrared images, sample results, and clear recommendations for containment and cleanup. This level of documentation is invaluable for insurance claims, landlord-tenant disputes, real estate transactions, and contractor bids because it provides an authoritative record of conditions and the steps required to resolve them. Our documentation also helps track progress during remediation and verifies that corrective actions addressed the root cause. By delivering comprehensive, easy-to-follow reports, we help clients coordinate with restoration professionals and maintain transparency throughout the process.
Experienced, Certified Team
Experience and proper training make a measurable difference in inspection quality. Our technicians are trained in industry-standard protocols, familiar with common building assemblies and moisture dynamics, and skilled at interpreting subtle signs of water intrusion. That expertise enables us to identify likely source points, advise on practical repairs, and recommend the most effective testing strategies. We follow safety and containment best practices when conducting inspections in affected areas and collaborate with remediation contractors when needed. Clients benefit from recommendations grounded in experience and evidence, which reduces the chance of misdiagnosis and repeated problems. Choosing a knowledgeable inspection team means confident, durable solutions rather than temporary fixes.
In summary, investing in a professional inspection delivers peace of mind, targeted solutions, and protection for both health and property. Our approach combines rapid, reliable response with objective testing, comprehensive documentation, and experienced technicians who prioritize fixing the root cause rather than masking symptoms. For homeowners and property managers, a proper inspection reduces the risk of recurring moisture and mold issues, supports insurance and real estate needs, and gives clear, defensible guidance for remediation. We work to make the process straightforward: schedule an inspection, receive a detailed report, and move forward with a remediation plan designed to restore a safe indoor environment. Let us help you understand the issue and take the right steps to protect your home and the people who live there.
Surface Sampling
Understanding what is on your surfaces is important for your health and safety. Certain types of mold can trigger allergies, breathing issues, and other health concerns, especially for children, seniors, and those with existing conditions. Surface sampling allows us to determine whether mold is present and if it may pose a risk. This information helps you decide what steps to take next, whether that means cleaning, repairs, or professional removal. Our surface sampling service in West Hollywood, CA
is designed to give you clear answers when you suspect mold on walls, ceilings, floors, or other surfaces in your home or business. Sometimes mold is easy to see, but many times it blends into the surface or looks like simple dirt or stains. Surface sampling helps confirm whether what you are seeing is mold and identifies the type present, so you can move forward with the right solution. This service is especially helpful when you notice discoloration, peeling paint, or unusual marks that do not go away with normal cleaning. Our trained professionals carefully collect samples from the affected areas using proper tools and methods. The process is quick, safe, and causes no damage to your property. We take care to work cleanly and respectfully, ensuring your space remains undisturbed during the visit.

Air Testing
Indoor air testing is a key part of modern mold inspection, and our air testing service in West Hollywood, CA
is designed to measure airborne mold spores and indoor contaminants that affect health and comfort. We use calibrated air samplers and follow industry-standard protocols to collect representative samples from living spaces, HVAC intakes, and problem areas. After sampling, we partner with accredited laboratories to quantitate spore counts and identify genera so you get reliable, science-based results. We interpret laboratory data for you, explaining what the numbers mean relative to outdoor baselines and whether they indicate an indoor source. Our technicians also recommend targeted actions — improved ventilation, source control, or remediation — based on findings and building conditions. This service is ideal for homeowners, landlords, and facility managers seeking reassurance about indoor air quality or verification after remediation work.

Moisture Mapping
Moisture mapping is an essential complement to mold inspection when water intrusion or persistent dampness is suspected. We create a detailed moisture profile of your property, using non-destructive tools like moisture meters, thermal imaging, and moisture probes where appropriate. The goal is to locate elevated moisture pockets in walls, ceilings, floors, and around plumbing or roof penetrations before mold becomes visible. We record moisture levels across rooms, mark problem zones, and track potential entry points such as flashing failures, gaps in seals, or poor drainage. With a moisture mapping in West Hollywood, CA
, you’ll see an evidence-based picture of where repairs are needed and how moisture is moving through the building envelope. Our recommendations focus on stopping water at the source, drying affected areas, and preventing conditions that support mold growth — a practical plan to protect building materials and occupant health.
We're the Best Mold Inspection Company Near You!
We know the climate and building styles in the area, which helps us identify mold risks more accurately. Whether you are a homeowner, renter, property manager, or business owner, we are ready to support you with reliable service and clear advice. We deliver reliable, thorough mold inspection services with a customer-first approach. Our technicians combine industry-trained expertise, modern testing equipment, and meticulous visual assessment to identify mold sources, affected materials, and moisture pathways. We prioritize clear communication through explaining findings in plain language, showing photos and test data, and outlining practical next steps. Rapid response matters, so we schedule inspections promptly and provide actionable reports that homeowners, property managers, and contractors can use immediately. Safety and discretion guide our work: we follow containment and sampling best practices to minimize disruption and limit cross-contamination. Whether it’s a small apartment or a large multi-unit building, our goal is to give property owners confidence in their indoor environment. For anyone facing suspected mold, we combine technical rigor with a compassionate, solutions-oriented service experience.
Building Lasting Success Through a Clear Mission and Vision
Our mission centers on protecting health and property by providing precise, evidence-based mold inspection services delivered with integrity and transparency. We believe accurate identification of mold conditions and moisture issues prevents recurrence and guides effective remediation. Our team invests in ongoing training, industry-standard protocols, and calibrated instrumentation so our findings are dependable and defensible. Community trust matters, so we emphasize responsiveness, clear explanations, and reports you can act on. Looking ahead, our vision is to be the trusted resource for mold evaluation across the region while promoting healthier indoor environments through education, prevention strategies, and collaborative problem-solving. We aim to raise awareness about moisture control and building science so clients can make informed decisions that protect occupants and investments. For residents and businesses, our approach combines technical excellence with practical, cost-conscious guidance.
Our Mission
Our mission is to provide homeowners, landlords, and property managers with accurate mold inspection services that prioritize safety, clarity, and long-term prevention. We focus on thorough assessment techniques to pinpoint sources of contamination and the environmental conditions that allow mold to thrive. Communication is central: we translate technical results into clear recommendations and step-by-step remediation plans so clients understand both urgency and options. We also emphasize proactive measures, advising on ventilation, drying strategies, and construction details that reduce future risk. Serving the local community with professionalism and respect, we work to ensure every inspection leads to a practical path forward and improved indoor air quality for families and occupants.
Our Vision
Our vision is to elevate standards for mold inspection by combining scientific rigor with accessible service. We see a community where property owners recognize early signs of moisture problems and seek timely evaluations, reducing health risks and costly repairs. To achieve that, we foster partnerships with remediation contractors, building professionals, and public health advocates so findings translate into effective corrective action. Innovation matters: we commit to adopting better testing methods, refining reporting formats, and using data to inform prevention strategies that address underlying causes rather than just symptoms. Ultimately, we want every client to feel informed, supported, and confident in the condition of their space. For those seeking dependable assessments, our aim is to be the first resource they trust for clear, objective guidance.
In closing, our mission and vision are grounded in delivering honest, actionable mold inspection services that protect people and places. We combine meticulous fieldwork, laboratory-backed analysis, and straightforward reporting so clients receive both the facts and a clear roadmap for resolution. Education is part of our service: we help property owners understand how moisture dynamics, building materials, and occupant habits influence mold growth, and we offer prevention tips tailored to each property. By maintaining high ethical standards, continuous training, and open communication, we strive to be a dependable partner during stressful situations involving indoor contamination. If you suspect mold or want to assess humidity and moisture risks, our team is committed to providing a thorough evaluation and practical recommendations to restore safety and peace of mind.
Mold Inspection FAQs
Mold Inspection questions are among the most common concerns homeowners have, especially when visible spots, persistent musty odors, or recent water problems occur. On this page, we answer the questions we hear most often about identifying, testing, and managing mold in homes. Our goal is to give clear, practical information about what an inspection involves, when to call a professional, and how results guide next steps. We explain the differences between visual checks, air testing, moisture mapping, and laboratory analysis so you can make informed decisions about safety, remediation planning, and preventing future growth. If something feels off in your home, these FAQs will help you understand when to act and what to expect from the process.
How do I know if I need a professional mold inspection?
If you see visible mold growth, smell a persistent musty odor, or have experienced recent water intrusion, it's wise to get a professional inspection. Hidden mold can develop behind walls, under flooring, in crawlspaces, and inside HVAC systems, and it won’t always be obvious. We also recommend inspections when occupants have unexplained allergy-like symptoms, when buying or selling a home, or after a major water event. A professional inspector uses moisture meters, thermal imaging, and targeted sampling to find hidden sources, determine the extent of contamination, and advise on safe next steps. Early detection reduces cleanup costs and health risks.
What does a standard mold inspection include?
A typical inspection begins with a thorough visual survey of the property, checking common problem areas like bathrooms, kitchens, basements, attics, and around windows and plumbing. We use moisture meters and infrared scanning to locate hidden dampness and suspect areas, then perform targeted air and surface sampling when needed. Detailed moisture mapping documents relative humidity and moisture levels across the home. We record findings with photos and notes and provide a clear assessment of mold presence and potential sources. When lab analysis is performed, results help distinguish types and concentrations of spores, guiding appropriate remediation planning and prioritization.
How long does an inspection and testing process usually take?
Inspection duration depends on property size and complexity. A standard single-family home inspection, including visual checks, moisture mapping, and infrared scanning, typically takes one to two hours. If air or surface samples are collected, sampling adds only a short amount of time on site, but laboratory analysis usually takes 48 to 72 hours to return results. For larger properties or more complex investigations, an inspection can take several hours, and lab turnaround may be longer. We aim to complete on-site work efficiently and provide clear next steps once results are available.
Will the inspection tell me exactly how to fix the mold problem?
An inspection provides the information needed to plan remediation, but the actual repair approach depends on findings. We identify sources of moisture, map affected areas, and, when appropriate, use lab analysis to characterize mold types and concentrations. Based on that data we prepare a remediation plan outlining containment, removal, cleaning, HVAC considerations, and any repairs to stop recurring moisture. For structural or plumbing repairs we may recommend qualified contractors. Our reports focus on practical, prioritized steps so you understand which actions are essential for safety, which improve indoor air quality, and how to prevent future growth.
Is laboratory analysis necessary before starting remediation?
Lab analysis is not always required, but it is very helpful in many situations. When mold is clearly visible and source and extent are obvious, remediation can proceed based on visual and moisture findings. Lab testing becomes important when visible signs are limited, when occupants have health concerns, when liability or real estate transactions are involved, or when willing to verify clearance after remediation. Laboratory results identify spore types and concentrations, which can influence containment and cleaning methods. We recommend testing when results will change the scope of work or provide documentation needed for insurance, real estate, or occupant health decisions.
How much does a mold inspection usually cost and do you provide estimates?
Inspection costs vary by property size, scope, and whether sampling is included. Basic visual inspections with moisture mapping and infrared scanning for a typical home often fall within a defined price range, while added services add to the cost. We provide transparent estimates after a brief intake to understand property size and concerns, and we can tailor services to budget and priorities. Estimates outline what’s included, anticipated lab fees, and recommended next steps so there are no surprises, and you can decide how comprehensive an evaluation you need.